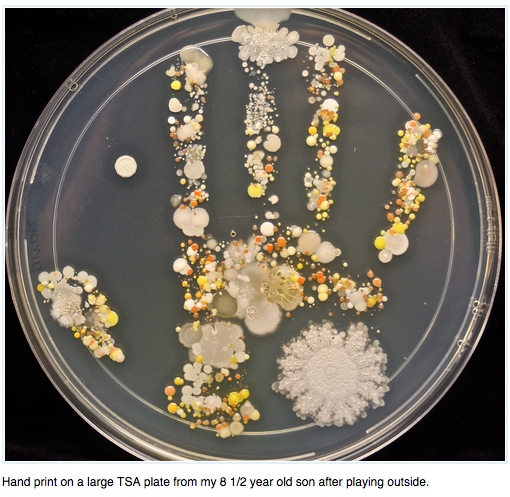

Todos hemos visto esas imágenes de los microorganismos que hay en las manos de un niño. En un experimento muy clásico, algo que todos hemos hecho para «enseñar» que hay bacterias, a un niño pequeño se le pone una mano sin lavar en una placa de cultivo, se le pide que la lave, y se repite. El resultado es asombroso, porque la mayor parte de las bacterias desaparecen tras el lavado de manos.
El problema de ese experimento es que se simplifica en exceso, y se suele omitir parte del contexto. Por una parte, cumple tan bien su función que a veces se lleva al extremo. Se concluye con demasiada facilidad que si el lavado es adecuado, se podrán eliminar todas las bacterias que hay en esas manos. Por otra parte, también se concluye que esas son todas las bacterias que hay en las manos.
¿Qué microorganismos hay en nuestras manos?
Lo primero que deberíamos aclarar es que ese tipo de experimento está diseñado para cultivar un tipo de microorganismos concreto: aquellos que pueden crecer en ese medio de cultivo. Así, seleccionamos algunas bacterias y hongos. Porque muchos hongos pueden alimentarse del mismo medio de cultivo que las bacterias, cosa que sabemos perfectamente porque recordamos aquello de la contaminación de las placas de cultivo con hongos que dio lugar al descubrimiento de la penicilina.
Si utilizamos una placa de cultivo, lo primero que aparecerán son colonias bacterianas, que son visibles pasadas unas 24-48 horas. Son los puntitos, más o menos grandes, con bordes más o menos lisos, y que tienen colores de lo más variados. Si cambiamos el medio de cultivo, podemos observar también cambios en el color del medio, incluso alrededor de la colonia, por acción de las bacterias. Y las propias colonias podrán cambiar su color, dependiendo de lo que hayan podido «comer» y liberar.
Hongos y virus
Pasadas las 48 horas empezarán a ser visibles los hongos. Aunque las levaduras pueden tener un aspecto similar, también veremos los hongos con el aspecto con el que todos los imaginamos: con sus fibrillas saliendo, similares al moho de un pan o de una fruta. Y es que pueden ser exactamente esos hongos, dependiendo de lo que tuviésemos en las manos.
Pero en las manos también tenemos virus. En algunos casos podríamos verlos, si se tratase de bacteriófagos que atacasen a las bacterias que hay en la placa, pero es algo raro. Para verlos tendríamos que poder cubrir la placa con bacterias, y ahí sí veríamos «agujeritos» que son las zonas en las que el virus ha eliminado a las bacterias. En cambio, los virus que atacan a nuestras células… esos no podemos cultivarlos en una placa para bacterias. Están ahí, pero no los vemos.
Las bacterias que no se ven
En cualquier caso, en esa placa vamos a ver siempre una pequeña fracción de lo que hay. Y es que la mayor parte de las bacterias no se pueden cultivar. No me refiero exclusivamente a las manos, me refiero a cualquier contexto: en el mundo, la mayor parte de las bacterias no se cultivan. Y como no podemos reproducirlas para ver lo que hay, si queremos identificarlas tenemos que recurrir a otras técnicas. Lo más común en esos casos es secuenciar los genomas presentes, y analizar su ARN ribosómico, que es lo que nos permite identificar mejor diferentes organismos.
Así sabemos que en las manos de cualquier persona, incluso en las manos más limpias, hay millones de microorganismos que no podremos cultivar en una placa, independientemente del medio de cultivo que utilicemos. Pero las bacterias que están en nuestra piel cumplen una función, y están bien ahí. Aunque cuando se nos descontrolan nos molestan, como nos puede pasar en la cara cuando tenemos granitos, la realidad es que gracias a ellas mantenemos la piel en buen estado, porque además evitan que tengamos otras infecciones.
¿De dónde salen los microorganismos de las manos?
Aunque toda nuestra piel tiene un montón de microorganismos, las manos son la zona en la que tenemos más diversidad. Y es lo normal, porque con las manos tocamos todo. Lo que acaba siendo la microbiota normal de nuestras manos se define en función de nuestro entorno, porque las recogemos en casa, en el trabajo, las intercambiamos con nuestros conocidos y también con nuestras mascotas. Últimamente, también eliminamos más de las que deberíamos, por un exceso de gel hidroalcohólico.
Para mantener una microbiota sana en nuestras manos, lo que deberíamos hacer es lavar las manos de forma frecuente con agua y jabón. Así eliminaremos las bacterias sobrantes, pero no afectará en exceso a las bacterias que son nuestras y se deben quedar ahí. Un poco de gel ocasional no es un problema, pero cuando abusamos alteramos esa microbiota, exponemos mucho más nuestras células, y acabamos con una piel reseca y con hueco para que otros microorganismos puedan crecer. Por ejemplo, un uso excesivo podría crear el ambiente ideal para la proliferación de un hongo, que aprovecha que es más resistente al alcohol y que hay menos bacterias, para establecerse en nuestra piel. Si además se forma un eczema, la cosa puede ser grave. Y si además afecta a las uñas, todavía peor.
¿Pero sabemos qué tenemos o no?
Realmente no tenemos nada claro que es lo normal, porque lo normal depende mucho de cada uno. Sabemos que hay algunos microorganismos que no deben estar en la piel, pero entre lo que hay, cada persona es un mundo, y puede haber muchos microbios distintos sin que ello suponga un problema.
Hay varios estudios al respecto, pero parece un campo que todavía no se ha estudiado en suficiente detalle y queda mucho camino por hacer, que además podría ayudar en el futuro a solucionar algunos problemas de la piel. Imaginad si acabásemos utilizando probióticos para la piel para tener unas manos más suaves… que no es descabellado. Pero aunque haya poco, algunos estudios hay, y revisiones también. Si queréis saber más, aquí os dejo una revisión de hace unos años, que básicamente concluye que lo normal es tener muchos bichos y muy diferentes. Así que vivamos tranquilos con nuestros microorganismos de la piel, que a ellos también tenemos que cuidarlos.
Para saber más: Review of human hand microbiome research
Si no quieres perderte lo que escribo, puedes suscribirte a mi newsletter. Para apoyarme en mi trabajo hay diversas opciones, como invitándome a un café:
[kofi]
Deja un comentario